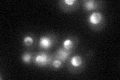
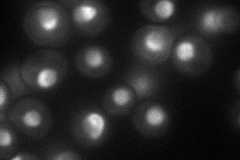
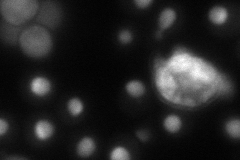
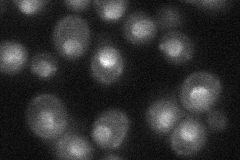
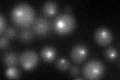
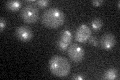

View description
Protein required for ribosomal large subunit maturation, functionally redundant with Ssf1p; member of the Brix family
Localization:
Intensity:
Fold change:
Significance:
-
C’ GFP library in SD
nucleus35.98 -
N' NOP1pr-GFP in SD
nuclear periphery57.6737 -
N' TEF2pr-mCherry in SD
nucleus,nucleolus48.9958 -
N' NATIVEpr-GFP in SD
nucleus31.6141 -
N' TEF2pr-VC and Cyto-VN in SD

#N/A0 -
C’ GFP library in SD+DTT
nucleus25.560.71No -
C’ GFP library in SD+H2O2

nucleus37.841.05No -
C’ GFP library in Starvation Media
punctateN/AN/AYes -
C’ GFP library on the background of Pup2-DaMP

nucleus -
C’ GFP library on the background of CCT mutant

nucleus33.95910.943369No
